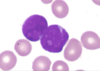

Rx misses Flashcards
Why does isoniazid cause peripheral neuropathy (numbnes & tingling)
- Isoniazid creates a functional pyridoxine deficiency (B6)
- prevented or reversed with vitamin B6 (pyridoxine) supplementation
Diag?
Name of cell on histo? Cells stain pos for what?

Acute promyelocytic leukemia (APL)– this is subtype of AML
Histo – Auer rods (purple needles in cyto),
-Stain pos for Myeloperoxidase
What type of cell?

Spherocytes (small round RBCs w/ no central pallor)
What are the signs of hypocalcemia
- Chvosteks sign = tapping facial nerve (tap the Cheek) –> contraction of facial muscles
- Trousseaus sign = carpal spasm upon bp cuff inflation
- Tetany
- Seizure
- QT prolongation
- Twitching
Diag?

Waterhouse-Friderichsen syndrome
= acute primary renal insufficiency d/t hemorrhage. Assoc w/ septicemia (N. meningitidis), DIC, shock
-Image shows sack of blood adrenal ***
Which nerve injury causes Trendelenburg sign?
Superior gluteal nerve (L4-S1)
-lesion is contralat to side of hip that drops. But lesion is ipsilat to the leg pt stands on
Which antiepileptic causes life threatening rash
Lamotrigene
- Life threatening rash = stevens-johnsons syndrome
- MOA: block voltage gated Na+ channels –> inh release of glutamate
Which heart condition are pts with Turners at risk for developing?
Coarctation of aorta
Schizoaffecive disorder diag
Schizophrenia + major mood disorder (MDD or bipolar) w/ psychotic features
- Schizophrenia: ≥2 sx for ≥1 mo (delusion, hallucination, disorganized speech, catatonic behavior, flattening, avolition, anhedonia asocial, alogia)- 1 sx must be first three.
- Major mood disorder
- Must have Psychotic features > 2 wks w/o mood episode
What does histo show?
What conditions do you see this in?

Caseating granuloma (has central necrosis), epithelioid histiocyte aggregation
- See this in TB & fungal infections
Which diseases assoc w/ HLA-B27
- Psoriatic arthritis (NOT RA)
- Ankylosing spondylitis
- IBD-associated arthritis (Chrons & UC)
- Reactive arthritis
PAIR
Organisms associated with IV drug abuse
- S. aureus
- Tricuspid valve Endocarditis
- Pnemonia
- Osteomyelitis
S.pneumoniae
- Pneumonia
- Candida albicans
- Tricuspid valve endocarditis
- Osteomyelitis
Pseudomonas
- Tricuspid valve endocarditis
- Osteomyelitis
HTLV –>Adult T cell lymphoma (neoplasma of mature T cells)
A 50-yo f
- generalized malaise and a nagging cough w/ hemoptysis. Today dark urine.
- PE: Diminished air entry in the lungs B/L and an ulcerated lesion of the mucosa of the right naris.
- No hx asthma or allergies.
- Urinalysis: (+) blood
- Cr= 1.7 mg/dL. (normal 0.6-1.2)
Granulomatosis w/ polyangiitis (Wegener)
- –> leads to RPGN (crescentic)
- Nephritic = azotemia (incr Cr), hematuria
- PR3/C ANCA in serum (vs eosinophilic granulomatosis w/ polyangiitis- churg-strauss- has Eosinophils in urine and has hx asthma/allergies but has ANCA)
- Lung and nose involvement (vs microscopic polyangiitis- very similar sx but no nose/upper resp)
- Focal necrotizing vasculitis
What is DLco in pulmonary function measurements?
= Diffusion capacity for carbon monoxide (DLCO) –(measures the general diffusion capacity)
- This indicates a reduced ability of the lungs to transfer gases from the alveolar sacs to the pulmonary capillaries and visa versa.
- Will be decr in COPD (emphysema)
- Will be incr in polycythemia, asthma, and increased pulmonary bl vol as occurs in exercise.
- 57-yo m, asymptomatic
- A blood smear shows neutrophils in all stages of maturity with an especially large number of immature myelocytes and segmented neutrophils compared to mature cells.
Laboratory results and blood smear are shown below:
Diag?

CML
-tx w/ tyrosine kinase inhibitors (imatinib, dasatinib)
A 45-yo obese f
- 2-day hx of intermittent ab pain, N/V.
- Sx worse after eating a hamburger & fries @ bbq yesterday.
- Smoker
- Fmhx HCC
diag?
Cholelithiasis
(4 Fs- fat, f, forty, fertile)
- 7-yo son
- bouts of perianal itching, which occur at night and disrupt his sleep.
- PE: mild erythema around the anus.
- physician instructs the mother to apply cellophane tape to the child’s anal area at night when the itching occurs and bring tape back for analysis.
The pediatrician observes the findings in image
Diag?

Enterobius vermicularis (pinworm)
Pneumonia in an IC pt is prob caused by which organism?
pneumocystis jirovecii
UTI
(-) nitrite
(+) leukocyte esterase
Foley catheter
Pt in hospital
Which organism caused UTI?
Enterococcus: bc (-) nitrite and nosocomial (HA) and catheter
- E.coli is most common cause but has (+) nitrite. Also klebsiella, serratia
- Staph sapro don’t see in nosocomial (HA) or catheter
CML tx
tyrosine kinase inhibitors (imatinib, dasatinib)
What does this histo show?
what conditions do you see this in?

- Non caseating granuloma (lack central necrosis-heach histiocyte has nu)
- Histo: big aggregate of epithelioid histiocytes (this makes it a granuloma). multinucleated giant cells inside, surrounded by lots of lymphocytes
- Conditions:
- Reactional to foreign material (ex- ruptured breast implant–> material leaks out)
- Sarcoidosis
- Beryllium exposure
- Chrons disease
- Catscratch disease– granulomas are stellate shaped
A 24-yo fintellectually disabled
- Having MI
- PE: tall, lanky body and lenses that are displaced both downward and inward.
Homocystinuria
- Sx
- Intellectual disability
- Marfanoid habitus– tall lanky body
- Down and inward eye lenses– lens subluxation
- Cardiac problems – MI
- Pathogenesis
- def cystathione synthase (B6 as cofactor) –> incr homocystine
- or def methionine synthase (B12 as cofactor) –> incr homocystine
What test to confirm c diff infection
Toxin assay (gold std)
- Can also use ELISA (faster, but less sensitive)
- c diff has 2 protein exotoxins (A and B) that cause the colitis
- toxin producing strains able ot survive bc of disruption of normal GI flora (d/t ABX)
Congenital condition
Diag?

Congenital diaphragmatic hernia (bowel moves into thorax)
CCK functions
- Released by i cells in duo –induced by fats in duo
- Action
- incr pancreatic secretions
- incr gallbladder contractions (would cause pain after fatty meal in cholelithiasis- 4 F’s)
- decr gastric emptying
- incr sphincter of oddi relaxation
- 42-yo f was in motor vehicle collision.
- was a restrained passenger in a car that struck a light post while traveling at a high speed.
- She is conscious and reports difficulty breathing and severe pain in her chest and back.
- CXR shows a widened mediastinum
Diag?
Traumatic aortic rupture
- d/t deceleration injury (high speed motor vehicle collision)
- Site of rupture is at aortic isthmus (prox descending aorta, just distal to orgin of L subclavian A)
CXR shows widened mediastinum
What does histo show?
Which micro organism you see this? (pt had BM transplant)

- Cowdry type A inclusion bodies are eosinophilic inclusions that occupy up to 1/2 of the nuclear volume
- HSV
Which HF drug for rate control causes visual disturbances, as well as nausea, vomiting, and diarrhea, aside from beta blockers
Digoxin
- coarse facial features
- clouded corneas
- restricted joint movements
- incr serum hydrolase levels
diag?
I-cell disease
- lysosomal storage disorder
- golgi fails to phosphorylate mannose –> secrete proteins extracellularly instead of to lysosomes for destruction.
- See lysosomal enzymes (hydrolase) in plasma
the probability that a positive test result with this new testing method is actually positive.
What is it called that you’re looking for?
PPV
Diag?

Neonatal RDS
-Ground glass opacities (diffuse interstit infiltrates)
- A 22 yo college student
- flu-like symptoms that have been present for about 1 week: low-grade fevers, night sweats, a painful sore throat, headaches, and increasing fatigue.
- “lack of energy.”
- Temp of 100.8°F (38.2°C) and respiratory rate of 12. His lungs are clear to auscultation bilaterally.
erythematous tonsils without exudates, enlarged cervical lymph nodes, and a palpable spleen tip.
Mono
1st line tx for non severe ulcerative colitis
Non severe means is not associated with anemia or cardiovascular effects (signs of severe disease)
-Treat w/ 5’-ASA preparations = mesalamine or sulfasalazine (a mesalamine prodrug)
What is an adjunct tx for COPD? in addition to inhaled steroids and beta agonist
Ipratropium bromide (muscarinic antagonist)
- competitively blocks muscarinic receptors, preventing Ach-mediated bronchoconstriction
- It is used to treat COPD and asthma, especially when β-agonists are insufficient
- 20 y.o
- night sweat, fever, weight loss
- LAD in neck and both armpits
- Lymph node bx shows?
Diag?

Reed sternberg cells (bi lobed nu in background of lymphocytes)
-Diag: Hodgkin lymphoma
20 yo (has bimodal distrubution– either young adult or > 55
Night, swear, fever = B sx
What does glucose do to Lac operon
Glucose blocks adenyl cyclase –> decr cAMP –> can’t activate CAP (catabolite activator protein) in order to induce transcription –> so no transcription
Which nephritis syndrome has Granular immunoglobulin and complement deposition
Diffuse prolif GN usually d/t SLE
-this shows up as “wire looping” of caps on LM
- construction worked
- Smoke & drink hx
- Dyspnea after moving to new area
- wheezing while at work
- Diag? Histo shows?

- Diag- bronchial asthma
- Histo: shows obstruction of the bronchial lumen with mucoid exudate, goblet cell metaplasia, and smooth muscle hypertrophy (upper right corner)
- Asthma can be triggered by envir causes, so the pts observation that he began experiencing increased dyspnea when he moved to the area is a clue here
- If a sputum analysis were performed, it would show eosinophils, hazy whorls of mucus known as Curschmann spirals, and Charcot-Leyden crystals (breakdown products of eosinophils, indicated in the image by the squares)
A 67 yo m
- often travels to Africa and Asia with his wife.
- Sx of HF
He drinks several glasses of wine every evening
PE: rlaterally displaced PMI, an S3
CXR large, balloon-shaped heart.
Diag?
Dilated cardiomyopathy
- can be d/t alcohol
- Sx: HF, S3, balloon heart on CXR –> enlarged cardiac silhouette

-Pt unresponsive, constricted pupils, decr bowel sounds, track marks on elbows
Blood pressure: 110/75 mm Hg
Respiratory rate: 4/min
Diag?
Pt has (metab/resp) (acidosis/alkalosis)
- Opioid toxicity - acute respiratory acidosis, bc:
- opioid tox causes depression of the central respiratory drive –can see his RR is greatly reduced (4/min)
- Would cause increase in CO2 d/t hypoventilation
- miotic pupils
- decreased bowel sounds
- There arecharacteristic signs of opioid toxicity
- opioid tox causes depression of the central respiratory drive –can see his RR is greatly reduced (4/min)
Which lipid lowering drug class has myopathy AE?
Also concommitant use with with drug increases the risk of myopathy?
FIbrates (“-fibr-“)
- gemfibrozil
- bezafibrate
- fenofibrate
incr risk for myopathy when using statins
Tx Enterobius vermicularis (pinworm)
Pyrantel pamoate, bendazoles
Which anti epiletic med causes agranulocytosis
Carbamazepine
ABG analysis values for respiratory acidosis
pH < 7.35
HCO3 (compensation) low
PCO2 > 44 mmHg
In which condition do you see call-exner bodies?
Ovarian tumors (granulosa cell tumor)
- has coffee bean nu
- They are eosinophilic, fluid-filled spaces

Pt SOB, dizziness, N/V, and arrhythmia (“heart beating our of my chest”) after recent smoke inhalation
- Tachypnea, hypotension, bright red Vs & As in eyes, acrid breath smell
- Pt given hydroxycobalamin for initial tx
- Cyanide poioning
- Cyanide strongly binds to the iron within cytochrome oxidase, thus interfering with the electron transport chain and inhibiting cellular respiration.
- commonly seen in the setting of household fires
- acrid (“bitter almonds”) smell on their breath
Diag?

Fragile X
- see long face, large everted ears, large jaw
- Other sx
- intellectual disability (2nd most common cause intellectual disability- 1st is downs)
- macroorchidism
- MVP
- macrocephalo
- Genetics
- trinucleotide repeat (CGG) –> anticipation
- FMR1 gene –> hypermethylation –> decr expression
- X-dom
Mild cold symptoms followed by a persistent paroxysmal cough
Bordatella pertusis
-paroxysmal cough = whooping cough
- 10 yo
- TdT+
Diag?
What does histo show?

ALL (acute lymphoblastic leukemia)
Histo = lymphoblast proliferation in BM
- 15-yo f
- lower abdominal pain, worse during vaginal intercourse.
- Yellowish vaginal discharge.
- uses oral contraception but does not use barrier protection; she has had three sexual partners in the past year.
- Temp = 100.9°F (38.3°C)
Pelvic examination reveals a normal appearing vulva and introitus; her cervix is friable, and there is purulent discharge coming from the cervical os
Diag?
Pelvic inflammatory disease
- cervical motion tenderness
- adnexal (uterus) tenderness
- purulent (yellow/green) cervical discharge
- D/t chlamydia or neisseria gonorrhaea
A firm, nonpainful, red lesion on the outside of the vagina and a maculopapular rash on the palms that appears several weeks later
Diag?
Primary syphilis
Drugs that cause gynecomastia
Ketoconazole, an antifungal
Finasteride, a 5-a-reductase inhibitor
Hormone-replacement therapy, estrogen and progesterone
Spironolactone, a mineralocorticoid receptor antagonist
Cimetidine, an H2-receptor antagonist
Digoxin, a cardiac glycoside
Antipsychotics; most are dopamine receptor antagonists
What does histo show?
what is organism?

- Histo: cysts with bradyzoites seen by the arrow
- Toxoplasma gondii
- Affect IC
- Cause brain abscess –> see mult ring-enhancing lesions on MRIs
Causes of anovulation (PALMI- CONE)
- Pregnancy, Polycystic ovarian syndrome, hyperProlactinemia
- Athletes, Adrenal insufficiency
- Cushings, Chrom abnormalities (ex-turner)
- Obesity
- Eating disorders
What type of blood cell is this?
Which disease do you see a proliferation of these
blast cell : large, less cyto, “punched- out” nucleolus?
see prolif of blast cell in acute leukemia

Which nephrotic syndrome has negative IF
Minimal change disease
- 58-yo m
- Smoker
- 4-mo hx of anorexia, weight loss, generalized weakness, and painless jaundice.
- 1 wk ago, he had pain in his Lcalf assoc with swelling and warmth. Today, says Lcalf has healed, but his R forearm is now swollen and painful.
- PE: painless enlargement in the RUQ of his abdomen.
Diag?
Pancreatic cancer
- -Risk factors: age > 50 yo, smoker, DM
- sx
- Weight loss, anorexia
- Migratory thrombophlebitis (Trousseau Syndrome) –> Red and tenderness of extremities - this is hypercoaguable state –> cause incr risk clotting events like DVT –> pulm emolism
- Jaundice with palpable non-tender gallbladder (Courvoisier sign)
- Marker: CA 19-9
- 46 yo f obese
- RUQ pain, w/ N/V that began 4 hours ago.
- Temp- 99.0°F (37.2°C)
- Physical exam: obese, moderate discomfort. Palpation in the RUQ elicits inspiratory arrest.
- Labs: incr WBC, amylase normal, AST = 20, ALT = 30
Diag?
Acute cholecystitis = d/t inflammation of gallbladder
- Sx
- RUQ pain
- (+) murphys = inspiratory arrest on RUQ d/t pain
- Labs:
- incr WBC (inflammation?)
- ALT > AST –> means liver problem
- Amylase normal (this is incr in pacreatitis, also lipase)
- Diag: US or chilescintigraphy (HIDA scan)–failure to visualize gallbladder on HIDA scan means obstruction
How to calculate renal CL if given: loading dose and desired plasma conc, and info saying constant IV infusion
CL = (0.7 x Vd)/ half life
Vd = Loading dose / (plasma drug conc x bioavailability)
Clearance is a pharmacokinetic measure of the volume of plasma from which a substance is completely removed per unit time
Red spots on the buccal mucosa, a rash that spreads caudally, cough, and conjunctivitis
-Diag?
Measles
Acarbose (diabetes med) AE
Diarrhea
Amiodarone has what lung AE?
Pulm fibrosis
“Rocker-bottom” feet are seen in which condition?
trisome 18 (edwards)
-don’t usually survive past age 5
Which N is damaged?

Midshaft humerus fracturs –> damage radial N
–> get wrist drop, decr grip strength, loss sensation post arm/forearm and dorsum hand
Tolbutamide AE
Tolbutamide is a 1st gen Sulfonylurea (along with chlorpropamide)
-AE for 1st gen = disulfuram-like rxns
In which conditions do you see migratory thrombophlebitis?
Adenocarcinoma of pancreas and lungs (Trousseau Syndrome)
Diag?
What do you see on EM?

Langerhan cell histiocytosis
- EM shows birbeck granulues (look like tennis rackets)
- also present w/ lytic bone lesion in child
Pt had flu, now has lobar pneumonia
-Which organism does histo show?

Staph aureus
- causes pneumonia (especially after influenza virus infection)
- staph is in clusters (vs strep- in chains–hemolysis)
Histone deacetylation activates or suppresses transcription
Suppresses (think acetyl groups so big-so knocks methyl groups out of the way–uninhibiting transcription)
What class of drugs cause drug induced parkinsonism?
Typical antipsychotics (haloperidol, pimozide, trifluoperazine, fluphenazine, thioridazine, chlorpromazine)
-Parkinsonism is EPS– get days to mos after meds
Benznidazole tx for
Chagas disease
- (trypanosoma cruzi)
- can cause- dilated CM, megacolon, megaesophagus
- See in S. america
- Also tx w/ nifurtimox
Liver bx
Diag?

- Shows ridging fibrosis around nodules in liver
- this fibrotic ridging is classicly for cirrhosis
- Can get cirrhosis from HCV
His arm hangs by his side, adducted, extended, and medially rotated. His forearm is pronated, and his hand is flexed at the wrist.
Erb’s Palsy (“waiters tip”)
-C5-C6 N roots of upper trunk injured
–> injured: deltoid, supraspinatus, infraspinatus, biceps
Child w/ Fever, arthralgias, and lymphadenopathy followed by a rash that spreads from the face down to the rest of the body
-this is d/t TORCHES infection. Which one?
Congenital rubella
-ToRCHeS organisms (Toxoplasmosis, Rubella, Cytomegalovirus, Herpesvirus/HIV, and Syphilis) that can cross the placenta and cause congenital disease.
thrombotic thrombocytopenic purpura (TPP) pathogenesis
Absenceor decreased amount vWF protease ADAMTS 13
Pt has infective endocarditis. Cause of chest pain is similar to what?
The vegetations that exist on the tricuspid valve can detach, embolize, and lodge themselves in the pulmonary circulation, resulting in a pulmonary embolism decondary to DVT –> L heart gets blocked
- 66-yo m c/o recent-onset fever, productive cough, and pleurisy.
- new-onset bone pain and fatigue with exertion. Pain is in back and is exacerbated with changes in position.
- nonsmoker and was in good health until the last few weeks.
- temp 38.4°C (101.1°F), pulse is 107/min, Ris 23/min, and his bp 110/90 mm Hg.
- PE thin, elderly male in mild respiratory distress with crackles and fremitus at the left lower base.
- MRI: hypodense lesions of vertebral bodies
- Electrophoresis shown
Diag?

Multiple Myeloma
- ≥10% of clonal plasma cells on BM biopsy .
- presence of monoclonal proteins in serum or urine, and myeloma-related organ dysfunction, such as hyperCalcemia, Renal insufficiency, Anemia), and lytic Bone lesions (CRAB mnemonic).
- Osteoclast lytic lesion shown on CT
- Back pain, also affect skull
- M-spike in electrophoresis

- woman undergo surgery after sustaining critical injuries
- A man claiming to be the patient’s husband frantically arrives at hospital. He produces a picture of himself along with the patient.
- He says he needs to know how his wife is doing and if she is going to be okay.
What do you do?
under HIPAA, physicians cannot disclose information about the patient regardless of proof of identity. At the same time, it would be unethical to cause undue distress to the family by refusing to disclose the patient’s condition, which is stable.
What does this histo show?
Where do you find it and which micro organism is it assoc w/?

- Langhans giant cells consist of macrophages that have fused together through activation by interferon-gamma
- See around caseating granulomas
- Assoc w/ mycobacterium TB (in IC) -manifests in the apical lobe of lung and is assoc w hemoptysis.
Primary virulence factor for Staph aureus
Protein A
50 yo
- Describe histo
- Diag?

CML
-Histo: abundance of all cells from myeloid lineage (granulocytes)- see full spectrum
Not AML bc age (AML- usually >65 yo)
CML = 45-85 yo
- 32-yo m, ecent immigrant from India, c/o diarrhea, ab pain, and unintentional weight loss of 2.3 kg (5 lb) over the past several wks.
- sx were initially mild but have persisted intermittently.
- stools are more frequent, liquid consistency, and are streaked with blood and mucus.
- PE: diffuse ab tenderness, worse in RUQ.
- Labs: Stool is heme pos
Diag
Entamoeba histolytica
- dystentary (bloody mucousy diarrhea)
- liver abscess– so liver pain RUQ
- see in tropic countries w/ poor sanitation (India here)
- Incr WBC so means infection
- Test stool for dSaveiag
- Histo: image by the typical flask-shaped ulcer in the intestinal mucosa

Which diabetic med targets PPAR regulators?
Glitazones/thiazolidinediones: (“-glitazone”)
- pioglitazone
- Rosiglitazone
Acute shortness of breath in healthy young children
Diag?
What part of lung affected?
aspiration of small objects
The R main bronchus is more vertical and wider than the L. Therefore aspirates are more likely to enter the R middle or inferior lobe if the pt is standing or sitting
-Part of lung affected is medium sized airways in the R lower lobe
Drug that tx Non-hodgkins lymphoma that is cell-cycle non specific
= Cyclophosphamide
Many chemotherapy drugs are used to treat non-Hodgkin lymphoma. However, of the choices listed, only cyclophosphamide is cell cycle nonspecific.
- It is an alkylating agent that covalently bonds to DNA at guanine N-7.
- Cyclophosphamide rapidly controls CA but is also very toxic (AE- hemorrhagic cystitis). Thus, it should be promptly replaced with a less damaging drug.
Ivermectin tx for
Onchocerca volvulus
- See skin changes bc loss elastic fibers and river blindness
- caused by f blackfly
- Alcoholic m
- 3 episodes hematemesis and severe chest pain
Diag?

Mallory-weiss syndrome
- = longitudinal esoph lacerations d/t severe vomit (so see in alcoholics & bulimics)
- Tears/lacerations are painful (vs esoph varices- not painful)
- CXR = normal. does not show emphysema (would be present in boerhaave- esoph rupture)

incr beta-hCG
uterine enlargement more than expected for gestational age
diag?

complete mole
-see “snow storm” appearance on US
A 64-yo f
-B/L hip pain that has worsened over the past year. Pain worse in the evening, and improves with rest.
Diag?
Osteoarthritis
-wear and tear disorder –> so see in older people and more pain with use.
MOA carbamazepine
Blocks Na+ channels
tx-bipolar, trigeminal neuralgia, partial & tonic clonic seizures
AE: agranulocytosis, aplastic anemia, livertox, teratogen, SIADH, steven johnsons
Cimetidine
- H2 blocker for acid suppression therapy in gastric parietal cell
- gastrin stim ECL cells –> release Histamine –> H2 receptor on parietal cell membrane –> stim Gs –> incr cAMP –> stim H/K ATPase –> release H (gastric acid) into gastric lumen
- AE cimetidine
- antiandrogen effects (PRL release, gynecomastic, impotence, decr libido in m)
- cross BBB (confusion, dizzy, headache), and placenta
- decr renal excr of Cr
- 70-yo m presents 3-day hx cramping pain LLQ.
- N, fever, constipation.
- Pmhx: HTN, hyperlipidemia, and DM
- PE: A particularly tender mass of tissue is palpated in LLQ
Diag?

Diverticulitis (formed from incr intraluminal pressure –> microperforation in diverticula)
- see sx inflamm (incr WBC, fever)
- CT findings of perisigmoid inflammatory changes, such as fat stranding. Bowel wall thickening
- Age > 60

Fever, fatigue, sore throat, body aches, malaise, and swollen glands
Diag?
nonspecific symptoms but are commonly seen in patients with infectious mononucleosis.
What is the most common site of traumatic aortic rupture

Aortic isthmus (prox descending aorta, just distal to origin of L subclavian A)
-in traumatic aortic rupture– get from deceleration injury. CXR shows widened mediastinum
Osteomyelotis in IV drug user, which organism caused?
Pseudomonas
Tx alcohol withdrawal with?
Benzo
vs- Thiamine– tx alcohol use disorder, but treatment of acute alcohol withdrawal is first focused on controlling psychomotor agitation and preventing progression to more severe withdrawal (delirium tremens, seizures).
vs- Haloperidol tx alcohol withdrawal in pt who suffer psychotic symptoms (ex- hallucination)
vs- Naltrexone- maintain sobriety
vs- Disulfiram help chronic alcoholism, but not good for a pt w/ acute risk of delirium tremens.
What kind of patients get the pneumonia caused by klebsiella
aspiration pneumonia in patients with diabetes or alcoholism and also with hospital-acquired pneumonia
Which bacteria is gram (+) alpha hemolytic that causes pneumonia
Strep pneumoniae
- encapsulated
- catalase (-)
- Optochin sensitive and bile soluble
- strep is in chains (vs staph- clusters)
Which anticoagulant class can be given subQ and does not require laboratory monitoring
LMWHs (indirect factor Xa inhibitors)
Risk factors for placenta previa
- prior c section
- multiparity
Placenta previa “a preview of the placenta is visible through cervix”
What does histo look like for seminoma
Large cells in lobules with watery cytoplasm (“fried egg” appearance)

which disorder causes decr GnRH, LH, FSH, and amenorrhea
Hyperprolactinemia
- Pt SOB, warm, N/V, dry cough
- Hx BM transplant
- CXR: B/L, symmetrical lower lobe peribronchovascular and alveolar processes.
Bronchoalveolar lavage results:
Diag?

CMV pneumonitis (this is common compl in transplant pts- especially 1-2 mo post transplant)
Histo = owl eye inclusions (large cells w/ intranu basophilic inclusions)
-CMV is an enveloped, double stranded linear DNA virus that is latent in mononuclear cells
FEV1 = 60%
FVC = 70%
FEV1:FVC = 81%
What type of lung disease?

Restrictive (ex-pulm fibrosis)
See incr release of specific cytokine form renal interstitial cells in which lung disease?
COPD –they have mild/mod hypoxemia w/o hypercapnia–but can get worse and develop
-Pts w/ puls ox < 92% are prone to developing compensatory erythrocytosis d/t incr release of EPO
Chronic hypoxia (secondary to conditions like chronic obstructive pulmonary disease) can be assoc w/ incr EPO production and secondary erythrocytosis.
-EPO is a cytokine produced by interstitial oxygen-sensing cells of the renal cortex.
Which organisms have IgA protease as virulence factor?
S pneumoniae, H. influenzae, Neisseria
= SHiN
Why are peple with reduced consciousness at risk of aspiration?
-have an impaired cough reflex with incomplete glottic closure
.
Pt w/ Inflammatory bowel disease– which one?
A biopsy specimen of her colon reveals inflammation confined to the mucosa and submucosa, as seen in the image.

UC
- mucosal and submucosal inflamm only
- lossof haustra –> “lead pipe”
- Compl: fulminant colitis, toxic megacolon, perforation
- Primary sclerosing cholangitis. Assoc P-ANCA
This patient’s condition is not associated with anemia or cardiovascular effects (signs of severe disease), so she should be treated with a first-line medication: mesalamine or sulfasalazine (a mesalamine prodrug)
Which anti acid drug causes gynecomastia
Cimetidine (an H2 blocker)
-has antiandrogenic effects (PRL release, gynecomastia, impotence, decr libido in m)
What does histo show?
Which organism?

- budding cells with pseudohyphae
- Candida albicans
Sx of acute myopathy
progressive muscle pain and weakness and an elevated creatine kinase (CK)
This would be the X-ray of a neonate with what condition?
neonatal respiratory distress syndrome (NRDS)
-d/t dipalmitoylphosphatidylcholine (the most important component of surfactant) is deficient as a result of prematurity.
-chest x-ray demonstrates atelectasis with air bronchograms and low lung volumes

Girl w/ PID
Histo shows cervical cell culture
Diag?

Histo = chalmydia trachomatis– shows intracellular inclusion bodies
Top bugs that cause PID: chlamydia (most common bacterial STI in united states) and neisseria gonorrhaea
- 80-yo m, diagnosed 2 mo earlier with HTN, c/o 1-month hx of increased urinary frequency.
- wakes up 3-4x per night to urinate and does not feel that he can completely empty his bladder when he urinates.
- PE reveals a firm, enlarged prostate with regular nodules.
- His PSA level is 3.0 ng/mL.
Diag?
Benign Prostatic hyperplasia
- Age >50 (elderly man)
- increased urinary frequency, nocturia with incomplete voiding. Also difficulty starting and stopping
- Smooth elastic firm enlargement prostate (enlarged prostate with irregular nodules). Hyperplasia NOT hypertrophy of peri urethral (lat and middle lobes) –> which compress urethra
- Determination of PSA level is not necessary to make a diagnosis of BPH. Keep in mind that the PSA level may be elevated in a patient with BPH (historically >4 ng/mL was considered elevated), but as in this patient, it is not always the case.
- Tx- Prazosin is a selective α1-receptor antagonist used to treat HTN, especially in patients who also have BPH
- also tx BPH w/ doxazosin & tamsulosin (both also selective alpha-1 blockers- but tamsulosin not for HTN

What does histo show?
Which organism?

- Histo: intranuclear basophilic inclusions, indicated by the arrow
- Adenovirus
- non-enveloped, double stranded linear DNA
- Affect IC but very rare
Cause of infertility in 26 yo guy that has been trying to conceive for 14 mo with hx of inguinal hernia repair
Inguinal surgery –> accidental ligation of vas deferens or obstruction d/t scar tissue –> defect sperm transport –> infertility
Why do you get pain after fatty meals in cholelithiasis
Fat in duo –> triggers CCK release –> gallbladder contracts in order to incr bile to emulsify the fat. However stone obstructs so get pain when gallbladder contracts.
Which enzyme causes homocystinura that uses B6 as a cofactor
cystathionine synthases uses B6
-methionine synthase also causes homocystinuria but uses B12 as cofactor
Pic from cervical lymph node bx
What does it show? Diag?

Hodgkin lymphoma
-histo: reed sternberg cells
- intellectual disability
- macroorchidism
- long fact
- everted ears
Diag?
Fragile X
- X- dom, FMR1 gene, trinucleotiderepeat (CGG)–> shows anticipation
What does a lesion in the subthalamic nu of brain cause?
Contralateral hemiballismus
= a rare movement disorder that results in wild, flailing movements of the limbs. Its emergence points to a structural lesion or metabolic dysfunction in the region of the subthalamic nucleus, its afferent or efferent pathways, or interconnected deep brain nuclei, usually on the side contralateral to the movements.

cystathione synthase uses what as a cofactor
B6
–def in B6 or cystathione synthase causes homocystinuria (down and in lens subluxation, intellectual disability, marfanoid habitus- tall lanky body, stroke or MI)
In which condition do you see reinke crystals?
testicular tumors (leydig cell tumor)
-They are plump, rod-like cytoplasmic inclusions

TB drug that causes red urine? MOA?
Rifampin
-inh bacterial RNA synthesis by binding DNA-dep RNA polymerase –> block transcription

Abciximab MOA
Bind gp IIb/IIIa receptor on platelets –> prevent platelet aggregation
- also eptifibatide and tirofiban do this
- Glanzmann thrombocytopenia has same mech ==> def IIb/IIIa receptor

Pheochromocytoma
- Tumor of adrenal medulla –> chromaffin cells –derived from neural crest
- Gross image shows BROWN tumor bc adrenal medulla is brown.
Klebsiella virulence factor
Capsular polysaccharide
Which disease affect gp IIb/IIIa
Glanzmann thrombocytopenia
- see defect platelet aggregation –> defect platelet plug
- Decr platelet sx: incr bleeding time, microhemorrhage, epistaxis, petechiae, purpura
young f w/ epilepsy c/o subacute dyspnea, fatigue and cough w/ foul-smelling sputum. Has fever, mild hypoxia,
-Diag?

Aspiration pneumonia
what is pterygium colli? In what condition do you see it?
= webbed neck
-see in Turners
Diag?

Normal
- fever
- disoriented
- sublingual jaundice

thrombotic thrombocytopenic purpura (TPP)
What does lactose do to the Lac operon (e. coli)
High lactose blocks repressor –> so Lac operon continues with transcription
What does histo show?
diag?

Noncaseating granulomas (Th1)
Diag: Chrons Disease

A 15-yo f c/o amenorrhea.
-mother reports that her pregnancy was normal, and she received standard prenatal care. Her other daughters, who are older, started their periods at age 13.
PE: 30th percentile for height, and appears obese with a short neck (see image). Her genitalia and breasts are Tanner stage I. Urine pregnancy test is negative.
Diag?

Turners Syndrome
- short stature
- primary amenorrhea
- cystic hygromas
- webbed neck.
Turner syndrome is a chromosomal disorder occurring in 1:3000 births. Patients with Turner are at heightened risk for developing coarctation of the aorta
Emphysema values for:
FVC
FEV1:FVC
FRC
decreased FVC and FEV1:FVC ratio and increased functional residual capacity.

What is the positive predictive value
the probability that people with a pos test actually have the disease (that they are really true positives)
PPV = (TP/ TP + FP)
Pt has CHF
What are these cells?

Hemosiderin-laden macrophages (AKA HF cells)
suggestive of prior episodes of pulmonary congestion and edema that arise from chronic heart failure.

Tx PCP pneumonia MOA?
TMP-SMX –interferes w/ Dihydrofolate reductase and dihydropteroate synthase
AE of Glitazones/thiazolidinediones (diabetes beds)
Water retention –> lead to HF and weight gain, edema
- drugs end in “-glitazone”
- MOA: target PPAR –> incr insulin sensitivity and adiponectin –> regl glu metab and FA storage
Diag?
Histo shows?

Infectious mononucleosis
Histo: atypical lymphocytes
Possible complications of coarctation of aorta
- HF
- cerebral hemorrhage (berry aneurysm)
- Aortic dissection –> rupture
- possible endocarditis
Vaginal itching and a mucopurulent discharge
-Diag?
Gonococcal infecion
Histo in multiple myeloma shows?
rouleaux formation (RBCs stacked like poker chips)
-also shows numerous plasma cells (clock face nu)

Diseases assoc w/ IV drug abuse
Pneumonia
- S. aureus
- S.pneumoniae
Tricuspid valve endocarditis (Don’t “TRI drugs”)
- S. aureus
- Candida albicans
- Pseudomonas
Adult T-cell lymphoma
- HTLV
Osteomyelitis
- Pseudomonas
- Candida
- S.aureus
What happens microscopically in CF from mut in CFTR gene
The most common mutation causing CF is the delta F508 mut, resulting in defective processing and cell trafficking from the endoplasmic reticulum to the Golgi apparatus
In what conditions would see dactylitis
= lymphedema in fingers (AKA sausage fingers)
- Sickle cell anemia compl (in the painful vaso-occlusive crisis)
- psoriatic arthritis (type of seronegative spondyloarthritis
- Turners
A 15-yo m w/ painless testicular mass.
-Mass iscommon germ cell tumor that is highly sensitive to radiotherapy. They are told their son has a good prognosis.
Diag?
Seminoma (most common testicular tumor)
- fried egg histo
- similar to dysgerminoma in f
Which is before (breathing w/ 1 lung that’s ventilated) and after transplant in pt w/ pulm fibrosis

B = before
D = after
Ventilation on one lung results in decreased resp volume as well as higher pressure resulting in decreased compliance. Compliance is the change in lung volume for a change in pressure and is expressed as ΔV/ΔP.
Which nerve can be damaged in heart surgery that has an effect on lungs?
R phrenic nerve –runs along the fibrous pericardium
–> can paralyze R diaphragm (see sx like dyspnea after exertion, decreased lung sounds on one side of the chest)

65 y/o
Diag? Name histo cells

CLL (chronic lymphocytic leukemia)
Histo = smudge cells
- 36-yo f w/ abnormal menstrual cycles
- only 3 menstrual periods during the past 9 mo–all lighter than usual.
- regular periods until 9mo ago
- Discontinued oral contraceptives 1 yr ago when she decided to be pregnant.
- Hx endometriosis–asymptomatic since ablative tx 3 yrs ago.
- Hx Hodgkin lymphoma– tx with chemotherapy @ 24 yo.
- PE: The vaginal mucosa atrophic w/ thinning of the rugae.
- Labs: incr LH & FSH. Low estrogen
Diag?
Primary ovarian insufficiency (= Preature ovarian failure)
- f reproductive age
- idiopathic usually, but also d/t chemo & radiation
- Sx menopause before age 40– incr LH & FSH, decr EST. Atrophic vag mucosa
- decr ovarian quality & quantity –> anovulatory cycles
Which disorders would you see “clubbing” in?
- CF (clubbing is possibly compl)
- hypertrophic osteoarthropathy (paraneoplastic syndrome of adenocarcinoma of lung)
- Bronchiectasis
- Idiopathic pulmonary fibrosis
What stage of meosis is the nondisjunction that causes down syndrome?
Meiosis I anaphase
-homologous chromosomes begin to separate to opposite poles
These cells stain positive for what stain?
bonus- what other cell stains pos for this stain?

TRAP (tartrate-resistant acid phosphatase)
diag: Hairy cell leukemia